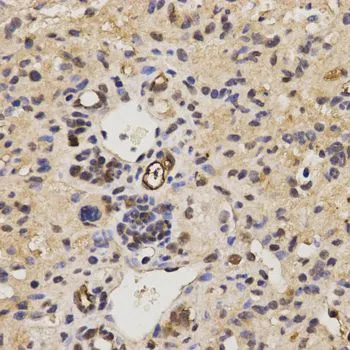

WB analysis of various sample lysates using GTX54018 RAI16 antibody. Dilution : 1:1000 Loading : 25microg per lane
RAI16 antibody
GTX54018
ApplicationsWestern Blot, ImmunoHistoChemistry, ImmunoHistoChemistry Paraffin
Product group Antibodies
TargetFHIP2B
Overview
- SupplierGeneTex
- Product NameRAI16 antibody
- Delivery Days Customer7
- Application Supplier NoteWB: 1:500 - 1:2000. IHC-P: 1:50 - 1:200. *Optimal dilutions/concentrations should be determined by the researcher.Not tested in other applications.
- ApplicationsWestern Blot, ImmunoHistoChemistry, ImmunoHistoChemistry Paraffin
- CertificationResearch Use Only
- ClonalityPolyclonal
- ConjugateUnconjugated
- Gene ID64760
- Target nameFHIP2B
- Target descriptionFHF complex subunit HOOK interacting protein 2B
- Target synonymsFAI16, FAM160B2, RAI16, RAM160B2, FHF complex subunit HOOK-interacting protein 2B, family with sequence similarity 160 member B2, protein FAM160B2, retinoic acid induced 16, retinoic acid-induced protein 16
- HostRabbit
- IsotypeIgG
- Protein IDQ86V87
- Protein NameProtein FAM160B2
- Storage Instruction-20°C or -80°C,2°C to 8°C
- UNSPSC12352203